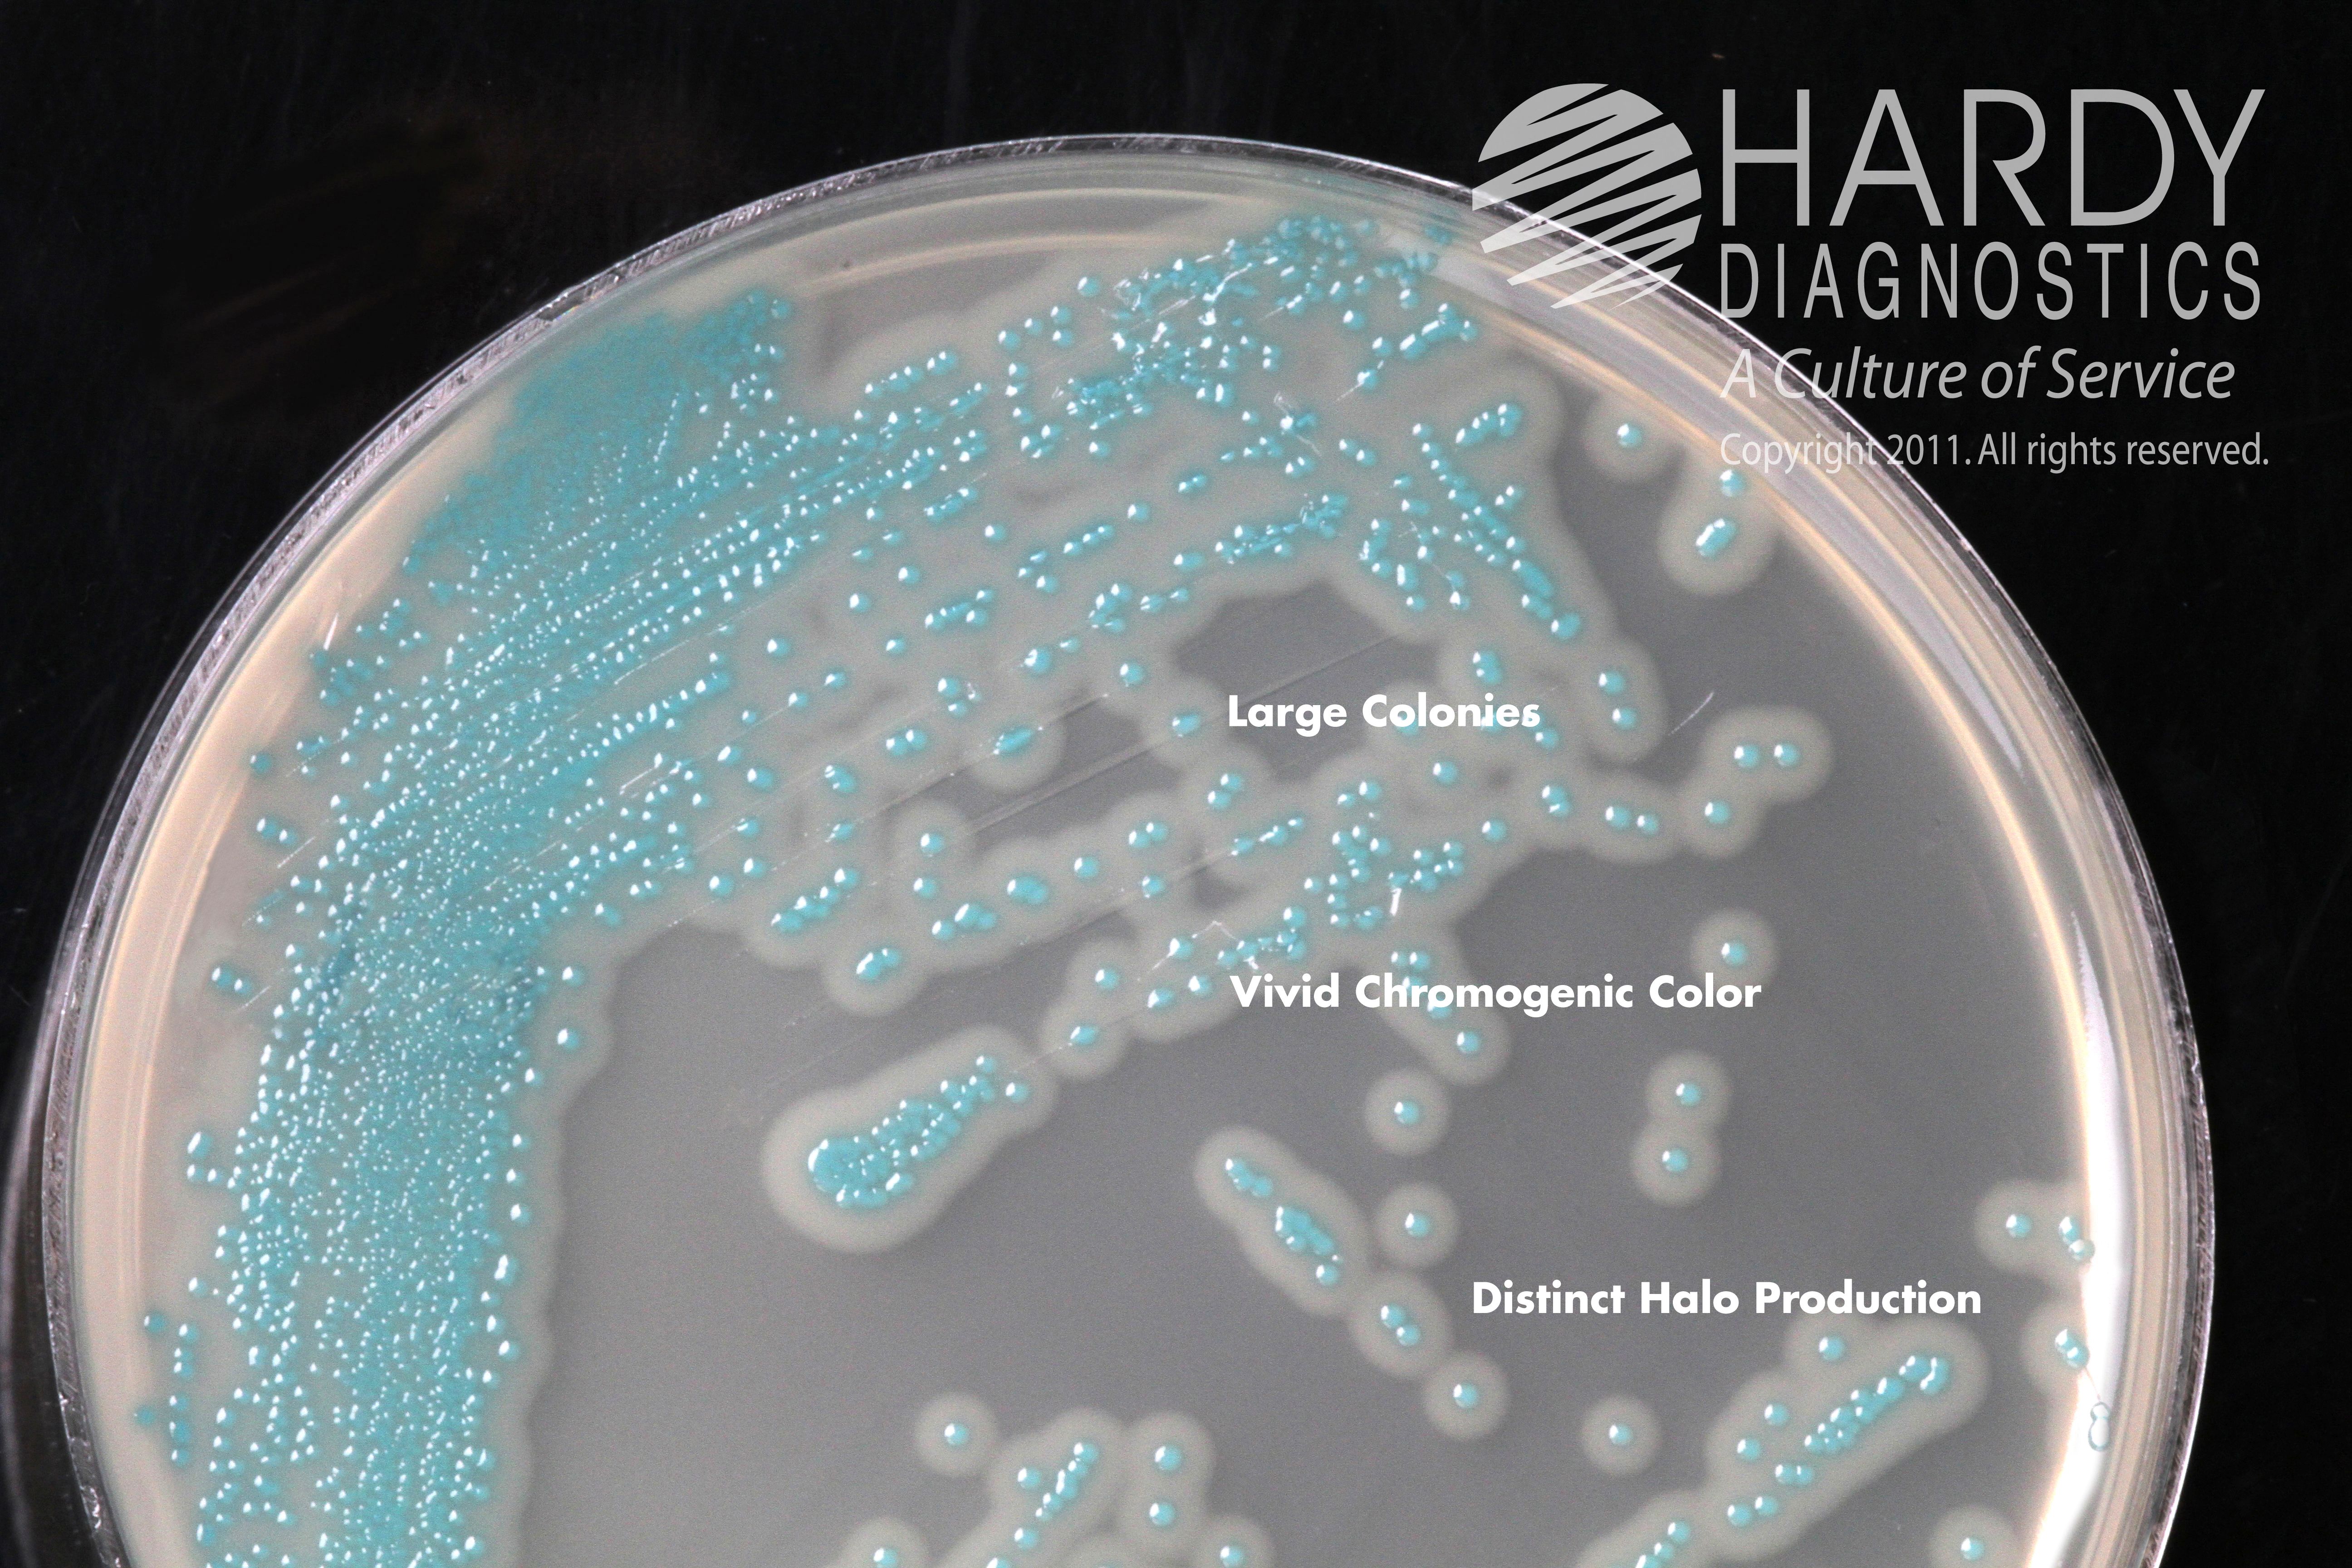
Listeria monocytogenes colonies

Möchten Sie immer auf dem neuesten Stand bleiben?
Erstellen Sie noch heute ein Leserkonto, um die Branchen und Unternehmen zu verfolgen, die Sie interessieren, und passen Sie Ihr Nachrichten-Dashboard an.
-
SANTA MARIA, Calif., March 14, 2022 (GLOBE NEWSWIRE) -- Hardy Diagnostics, a leader in manufactured and distributed microbiology products, is pleased to announce it is now the exclusive distributor...
-
SANTA MARIA, Calif., Jan. 26, 2022 (GLOBE NEWSWIRE) -- Hardy Diagnostics announces new TRIO.SETTLE stands, specially designed for passive microbial air monitoring. Hardy Diagnostics is an ISO 13485...
-
SANTA MARIA, Calif., Oct. 20, 2021 (GLOBE NEWSWIRE) -- Hardy Diagnostics is pleased to announce its release of HardyCHROM™ Candida + auris, a chromogenic media recommended for the selective...
-
SANTA MARIA, Calif., Sept. 21, 2021 (GLOBE NEWSWIRE) -- Carbapenemase-resistant Enterobacterales (CRE) are a major concern for patients in health care facilities. Some bacteria in this family are...
-
Santa Maria, Feb. 09, 2016 (GLOBE NEWSWIRE) -- SANTA MARIA, CALIFORNIA, February 9 – Hardy Diagnostics announced today the acquisition of GG&B Company in Wichita Falls, Texas, maker of...
-

Santa Maria, California, Jan. 5, 2015 (GLOBE NEWSWIRE) -- Hardy Diagnostics, an FDA licensed and ISO certified biomedical manufacturer, is pleased to announce the release of Compact Dry, a simple...
-
SANTA MARIA, Calif, Oct. 12, 2011 (GLOBE NEWSWIRE) -- Hardy Diagnostics, an ISO certified biomedical firm, is pleased to announce the release of HardyCHROM™ Listeria, a chromogenic medium...
-

Santa Maria, California, Sept. 19, 2011 (GLOBE NEWSWIRE) -- INC Magazine has once again included Hardy Diagnostics in their list of the 5,000 fastest growing private companies in America. Hardy...